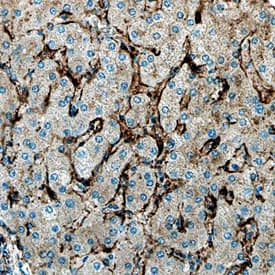
Arylsulfatase B/ARSB antibody in Human Liver by Immunohistochemistry (IHC-P).

Human Arylsulfatase B/ARSB Antibody
R&D Systems, part of Bio-Techne | Catalog # AF4415


Conjugate
Catalog #
Key Product Details
Species Reactivity
Human
Applications
Immunohistochemistry, Western Blot, Simple Western
Label
Unconjugated
Antibody Source
Polyclonal Sheep IgG
Product Specifications
Immunogen
Chinese hamster ovary cell line CHO-derived recombinant human Arylsulfatase B/ARSB
Ser37-Met533 (Val376Met)
Accession # P15848
Ser37-Met533 (Val376Met)
Accession # P15848
Specificity
Detects human Arylsulfatase B/ARSB in direct ELISAs.
Clonality
Polyclonal
Host
Sheep
Isotype
IgG
Scientific Data Images for Human Arylsulfatase B/ARSB Antibody
Detection of Human Arylsulfatase B/ARSB by Western Blot.
Western blot shows lysates of HepG2 human hepatocellular carcinoma cell line, Huh-7 human hepatoma cell line, and human skeletal muscle tissue. PVDF Membrane was probed with 1 µg/mL of Sheep Anti-Human Arylsulfatase B/ARSB Antigen Affinity-purified Polyclonal Antibody (Catalog # AF4415) followed by HRP-conjugated Anti-Sheep IgG Secondary Antibody (HAF016). A specific band was detected for Arylsulfatase B/ARSB at approximately 52 kDa (as indicated). This experiment was conducted under reducing conditions and using Immunoblot Buffer Group 1.Arylsulfatase B/ARSB in Human Liver.
Arylsulfatase B/ARSB was detected in immersion fixed paraffin-embedded sections of human liver using Sheep Anti-Human Arylsulfatase B/ARSB Antigen Affinity-purified Polyclonal Antibody (Catalog # AF4415) at 3 µg/mL overnight at 4 °C. Before incubation with the primary antibody, tissue was subjected to heat-induced epitope retrieval using Antigen Retrieval Reagent-Basic (CTS013). Tissue was stained using the Anti-Sheep HRP-DAB Cell & Tissue Staining Kit (brown; CTS019) and counterstained with hematoxylin (blue). Specific staining was localized to endothelial cells in bile canaliculi. View our protocol for Chromogenic IHC Staining of Paraffin-embedded Tissue Sections.Detection of Human Arylsulfatase B/ARSB by Simple WesternTM.
Simple Western lane view shows lysates of HepG2 human hepatocellular carcinoma cell line, loaded at 0.2 mg/mL. A specific band was detected for Arylsulfatase B/ARSB at approximately 59 kDa (as indicated) using 10 µg/mL of Sheep Anti-Human Arylsulfatase B/ARSB Antigen Affinity-purified Polyclonal Antibody (Catalog # AF4415) followed by 1:50 dilution of HRP-conjugated Anti-Sheep IgG Secondary Antibody (HAF016). This experiment was conducted under reducing conditions and using the 12-230 kDa separation system.Applications for Human Arylsulfatase B/ARSB Antibody
Application
Recommended Usage
Immunohistochemistry
5-15 µg/mL
Sample: Immersion fixed paraffin-embedded sections of human liver
Sample: Immersion fixed paraffin-embedded sections of human liver
Simple Western
10 µg/mL
Sample: HepG2 human hepatocellular carcinoma cell line
Sample: HepG2 human hepatocellular carcinoma cell line
Western Blot
1 µg/mL
Sample: HepG2 human hepatocellular carcinoma cell line, Huh‑7 human hepatoma cell line, and human skeletal muscle tissue
Sample: HepG2 human hepatocellular carcinoma cell line, Huh‑7 human hepatoma cell line, and human skeletal muscle tissue
Formulation, Preparation, and Storage
Purification
Antigen Affinity-purified
Reconstitution
Sterile PBS to a final concentration of 0.2 mg/mL. For liquid material, refer to CoA for concentration.
Formulation
Lyophilized from a 0.2 μm filtered solution in PBS with Trehalose. See Certificate of Analysis for details.
*Small pack size (-SP) is supplied either lyophilized or as a 0.2 µm filtered solution in PBS.
*Small pack size (-SP) is supplied either lyophilized or as a 0.2 µm filtered solution in PBS.
Shipping
Lyophilized product is shipped at ambient temperature. Liquid small pack size (-SP) is shipped with polar packs. Upon receipt, store immediately at the temperature recommended below.
Stability & Storage
Use a manual defrost freezer and avoid repeated freeze-thaw cycles.
- 12 months from date of receipt, -20 to -70 °C as supplied.
- 1 month, 2 to 8 °C under sterile conditions after reconstitution.
- 6 months, -20 to -70 °C under sterile conditions after reconstitution.
Background: Arylsulfatase B/ARSB
ARSB, also known as N-acetylgalactosamine-4-sulfatase, is a lysosomal glycoprotein and one of at least nine human arylsulfatases that catalyze the hydrolysis of sulfate ester bonds. ARSB deficiency is causative of the lysosomal storage disease Mucopolysaccharidosis VI. Human ARSB is cleaved intracellularly into fragments which remain associated with a disulfide linkage. Mature human ARSB (aa 37-533) shares 80% amino acid sequence identity with mouse and rat ARSB.
Alternate Names
ARSB, ASB, N-acetylgalactosamine-4-sulfatase
Gene Symbol
ARSB
UniProt
Additional Arylsulfatase B/ARSB Products
Product Documents for Human Arylsulfatase B/ARSB Antibody
Product Specific Notices for Human Arylsulfatase B/ARSB Antibody
For research use only
Loading...
Loading...
Loading...
Loading...
Loading...